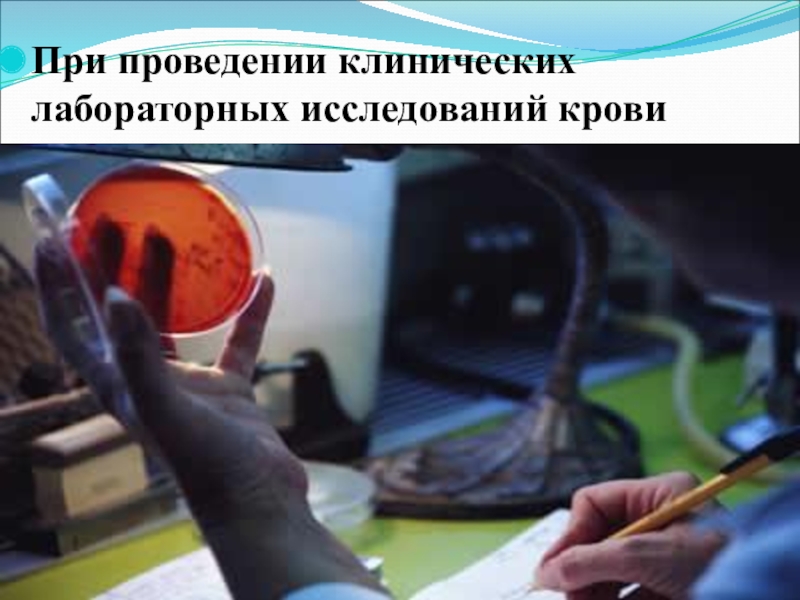

Разделы презентаций
- Разное
- Английский язык
- Астрономия
- Алгебра
- Биология
- География
- Геометрия
- Детские презентации
- Информатика
- История
- Литература
- Математика
- Медицина
- Менеджмент
- Музыка
- МХК
- Немецкий язык
- ОБЖ
- Обществознание
- Окружающий мир
- Педагогика
- Русский язык
- Технология
- Физика
- Философия
- Химия
- Шаблоны, картинки для презентаций
- Экология
- Экономика
- Юриспруденция
Одноатомные спирты
Содержание
- 1. Одноатомные спирты
- 2. Цель урока: - актуализировать знания о свойствах, получении и применении предельных одноатомных спиртов.
- 3. Задачи: - установить зависимость свойств предельных одноатомных
- 4. История открытия спиртовВпервые спирт из вина получили
- 5. Спирты (Алкоголи) – – производные углеводородов, в
- 6. Действие спиртов на организм
- 7. Алкоголизм – социальная болезнь В течение
- 8. АЛКОГОЛЬ — ЛИЧНЫЙ ВРАГ КАЖДОГОЭтиловый спирт (C2H5OH)
- 9. Слайд 9
- 10. Строение предельных одноатомных спиртовОбщая формула:СnH2n+1OHR → O
- 11. НоменклатураСН3ОН метанол (метиловый спирт)С2Н5ОН этанол
- 12.
- 13. ИзомерияС4Н10ОСтруктурная изомерия:1.Изомерия углеродного скелета:а) СН3-СН2−СН2−СН2-ОН бутанол-1б) СН3-СН−СН2−ОН
- 14. II.Классификация спиртов СН3 – СН2 –
- 15. I.Классификация спиртовСН3 – СН – СН3
- 16. III.Классификация спиртовСН3–СН–СН2 –ОН
- 17. Получение предельных одноатомных спиртов В быту:Получение этилового
- 18. Промышленным способом:Получение метанола из синтез-газа Метанол получают
- 19. Физические свойствапредельные одноатомные спирты от С1 до
- 20. Химические свойства1.Взаимодействие со щелочными металлами C2H5OH+2Na →
- 21. Демонстрационные опытыФизические свойства этилового спирта«Несгораемый платочек»Описание опыта:
- 22. Получение лекарственных веществПрименение спиртов
- 23. Этанол используется для обеззараживания
- 24. При производстве лаков и красок
- 25. При проведении клинических лабораторных исследований крови
- 26. Этанол можно использовать в качестве топлива для автомобилей
- 27. Его добавляют в реактивное топливо
- 28. Этанол – хороший растворитель для многих веществ, например йода
- 29. Сырьё для органического синтеза: синтетический каучук, из которого делают резину
- 30. Этанол – важное сырьё для органического синтеза: уксусной кислоты
- 31. Этанол является компонентом винаЭтанол является компонентом пива
- 32. Тест 1. Общая формула предельных одноатомных спиртов:
- 33. 4. При нагревании этанола выше 1400 C в
- 34. 7. Продукты реакции в реакции горения:
- 35. Это возможно проверить разными способами.Медную проволоку, скрученную
- 36. Домашнее заданиеОтветить на следующие вопросы:Дайте определение предельных
- 37. Спасибо за внимание!
- 38. Скачать презентанцию
Слайды и текст этой презентации
Слайд 2Цель урока:
- актуализировать знания о свойствах, получении и применении
предельных одноатомных спиртов.
Слайд 3Задачи:
- установить зависимость свойств предельных одноатомных спиртов от их
строения;
обобщить способы получения спиртов;
выявить области применения.
Слайд 4История открытия спиртов
Впервые спирт из вина получили в VI—VII веках
арабские химики: способ получения спирта содержится в записях персидского алхимика
Ар-Рази. В Европе этиловый спирт был получен из продуктов брожения в XI—XII веке, в Италии.В Россию спирт впервые попал в 1386 году, когда генуэзское посольство привезло его с собой под названием «аква вита» и презентовало царскому двору.
В 1661 году английский химик Роберт Бойль впервые получил метанол перегонкой древесины. Абсолютированный этанол из его водного раствора был впервые получен в 1796 году русским химиком Т. Е. Ловицем при перегонке над поташом.
В 1850 году английский химик Александр Вильямсон, исследуя реакцию алкоголятов с этилиодидом, установил, что этиловый спирт является производным воды с одним замещённым атомом водорода, экспериментально подтвердив формулу C2H5OH.
Слайд 5Спирты (Алкоголи) –
– производные углеводородов, в молекулах которых один
или несколько атомов замещены на соответствующее число гидроксильных групп (–ОН)
Функциональная группа спиртов:
-ОН
Слайд 6 Действие спиртов на организм
При содержании спирта 0,1%
в крови человек уже не может управлять автомобилем;
При 0,25% алкоголя
в крови человек теряет координацию движений,;При 0,35% - происходит полная потеря ощущений, а при 0.4% - наступает смерть.
Слайд 7Алкоголизм – социальная болезнь
В течение алкоголизма, как болезни
выделяют три стадии
Первая стадия:
- появляется непреодолимая тяга к
спиртному;- выпадают из памяти отдельные эпизоды периодов опьянения;
- утрачивается контроль над количеством выпитого.
Вторая стадия
- похмельный синдром;
- появление запоев;
- увеличение количества принятого алкоголя более 300 мл. в сутки;
- у больного алкоголизмом меняется характер, появляется агрессия, жизненные интересы сужаются,
Третья стадия
- появление признаков деградации личности и развитие слабоумия;
- появление необратимых патологических изменений во всех органах и системах человека, наличие признаков хронической алкогольной интоксикацией, поражения головного мозга, печени, сердца, внутренних органов это приводит к инвалидности.
Слайд 8АЛКОГОЛЬ — ЛИЧНЫЙ ВРАГ КАЖДОГО
Этиловый спирт (C2H5OH) вызывает поражение сердечнососудистой
системы, в том числе в виде алкогольной гипертонии и поражения
миокарда. На электрокардиограммах людей, отравляющих себя спиртными изделиями, замечаются значительные изменения. Обычными становятся перебои в сердечной деятельности (аритмия).
Метиловый спирт (древесный спирт, карбинол, метилгидрат, гидроксид метила) — CH3OH, простейший одноатомный спирт, бесцветная ядовитая жидкость. Метанол — это первый представитель гомологического ряда одноатомных спиртов.
Метанол — опаснейший яд, приём внутрь порядка 10 мл метанола может приводить к тяжёлому отравлению (одно из последствий — слепота), попадание в организм более 80-150 миллилитров метанола (1–2 миллилитра чистого метанола на килограмм тела) обычно смертельно.
Слайд 11Номенклатура
СН3ОН метанол (метиловый спирт)
С2Н5ОН этанол (этиловый
спирт)
С3Н7ОН пропанол (пропиловый спирт)
3
2 1СН3-СН2-СН2-ОН
пропанол-1
(пропиловый спирт)
1 2 3
СН3-СН-СН3 |
ОН
пропанол-2
(изопропиловый спирт)
5 4 3 2 1
СН3-СН-СН2-СН-СН3
| |
CH3 ОН
4-метилпентанол-2
Слайд 13Изомерия
С4Н10О
Структурная изомерия:
1.Изомерия углеродного скелета:
а) СН3-СН2−СН2−СН2-ОН бутанол-1
б) СН3-СН−СН2−ОН
|
СН32-метилпропанол-1
2.Изомерия положения функциональной группы:
а) СН2-СН2−СН2−СН3
|
OH бутанол-1
б) СН3-СН−СН2−СН3
|
OH бутанол-2
Слайд 14II.Классификация спиртов
СН3 – СН2 – OH
(этиловый спирт)
СН2 – СН2
| |
ОН ОН
этандиол- 1,2
(этиленгликоль)
СН2 – СН – СН2
| | |
ОН ОН ОН
пропантриол-1,2,3
(глицерин)
Слайд 15I.Классификация спиртов
СН3 – СН – СН3
|
OH
пропанол-2(изопропиловый спирт)
СН2 = СН – СН2 – ОН
пропен-2-ол-1
(аллиловый спирт)
Слайд 16III.Классификация спиртов
СН3–СН–СН2 –ОН
|
СН3
2-метилпропанол-1
(изобутиловый спирт)
СН3–СН–СН2–СН3
|ОН
бутанол-2
(вторичный бутиловый спирт)
СН3
|
СН3 – С – СН3
|
ОН
2-метилпропанол-2
(третичный бутиловый спирт)
Слайд 17Получение предельных одноатомных спиртов
В быту:
Получение этилового спирта из самогонного аппарата
Принцип
действия самогонного аппарата основан на различии температур кипения этилового спирта
и воды. Спирт закипает уже при 78ºС, а вода при 100ºС.Принцип работы самогонного аппарата довольно прост и основан на простой дистилляции, при которой в одной емкости брага нагревается, а пар, который выделяется при этом, конденсируется и оседает в другой емкости в виде готового продукта.
Слайд 18Промышленным способом:
Получение метанола из синтез-газа
Метанол получают в промышленности восстановлением
монооксида углерода при 400° С под давлением 20-30 МПа в
присутствии катализатора, состоящего из оксидов меди, хрома, и алюминияГидратация этилена (- Н2О)
Брожение
Этанол образуется и при так называемом спиртовом брожении сахаров, например, глюкозы С6Н12О6. Процесс протекает в присутствии дрожжевых грибков и приводит к образованию этанола и СО2:
Слайд 19Физические свойства
предельные одноатомные спирты от С1 до С12 – жидкости
высшие спирты – мазеобразные вещества
от С21 и выше – твердые вещества1. Агрегатное состояние
2. Плотность
легче воды
3. Температура кипения
• t кип. спиртов нормального строения увеличивается с увеличением молекулярной массы
• t кип. спиртов нормального строения выше t кип. спиртов изостроения
4. Растворимость в воде
С увеличением молекулярной массы снижается.
Метиловый, этиловый и пропиловый спирты хорошо растворимы.
5. Горючесть
Слайд 20Химические свойства
1.Взаимодействие со щелочными металлами
C2H5OH+2Na → C2H5ONa+H2↑
2.Взаимодействие с
галогеноводородами
C2H5OH+HBr →C2H5Br +HOH
3.Отщепление воды
C2H5OH→ CH2=CH2+H2О
4.Отщепление водорода
(дегидрирование) 5.Реакции горения спиртов
C2H5OH+3O2=2CO2+3H2O
Слайд 21Демонстрационные опыты
Физические свойства этилового спирта
«Несгораемый платочек»
Описание опыта: прополощите в воде
носовой платок, затем слегка отожмите его (так, чтобы он был
достаточно влажным) и хорошо пропитайте спиртом.Захватите платок за один из его концов тигельными щипцами и, держа их в вытянутой руке, поднесите к ткани длинную лучинку (опыт должны проводить два человека). Спирт сразу вспыхнет - создается впечатление, что горит платок. Но горение прекращается, а платок остается невредимым, так как температура воспламенения влажной ткани значительно выше, чем температура воспламенения спирта.
Химические свойства этилового спирта
1.Изучение кислотных свойств спиртов
В пронумерованных пробирках находятся щелочь (№1), кислота (№2), вода (№3). Испытайте эти вещества лакмусовой бумажкой. Опустите лакмусовую бумажку в этиловый спирт. Что наблюдаете? Сделайте вывод.
2. Реакции дегидратации
К 1мл спирта добавьте несколько капель Н2SO4 (конц.). Слегка подогрейте смесь. Осторожно вылейте содержимое пробирки в стакан с водой. Обратите внимание на запах. Это диэтиловый эфир (медицинский эфир).
Слайд 32Тест
1. Общая формула предельных одноатомных спиртов:
а) CnH2n+2
б) CnH2n
в) CnH2n-2
г) CnH2n+1OH
2. Функциональная группа
предельных одноатомных спиртов:
а) - СНО
б) - СООН
в) - ОН
г) - СН3
3. Промышленный способ получения
спиртов:
а) гидролиз галогеналканов
б) из синтез – газ
в) гидрирование этилена
г) гидролиз алкиновСлайд 334. При нагревании этанола выше 1400 C в присутствии Н2SO4получается:
а) этиленгликоль
б) этилен
в) ацетилен
г) диэтиловый эфир
5. Классифицируйте спирт: СН3 -
СН2 - СН2-ОН а) одноатомный, третичный спирт б) одноатомный, вторичный спирт в) трехатомный, первичный спирт г) одноатомный, первичный спирт
6. Вещество CH3 - CH(СН3) - CH2OH называется: а) изобутанол б) 2 - метилпропанол - 1 в) 2,2 - диметилэтанол г) 2 - метилпропанол - 3
Слайд 347. Продукты реакции в реакции горения:
а) углекислый
газ и вода
б) эфир
в) соль
г) вода8. Предельным одноатомным спиртом не является:
а) метанол
б) 3-этилпентанол-1
в)2-фенилбутанол-1
г) этанол
9. Изомером положения функциональной группы для пентанола-2 является:
а) пентанол-1
б) 2-метилбутанол-2
в) бутанол-2
г) 3-метилпентанол-1
10 .Одним из продуктов реакции, протекающей при нагревании метанола с концентрированной. серной кислотой, является:
а) CH2=CH2
б)CH3-O-CH3
в) CH3Cl
г) CH4
Слайд 35Это возможно проверить разными способами.
Медную проволоку, скрученную на конце спиралью
и раскаленную докрасна на огне, нужно погрузить в метиловый спирт.
Можно четко ощутить очень неприятный запах формальдегида. Его невозможно перепутать с другими запахами. Этиловый спирт не дает такого эффекта.Спирт поджечь и проследить за цветом огня. Этиловый спирт горит пламенем синего цвета, у технического спирта оно зеленого цвета.
Проверить спирт картошкой. Кусочек сырой картошки нужно положить в сосуд со спиртом. Если через несколько часов цвет картофеля не изменился, это говорит о том, что это пищевой, этиловый спирт. Его можно пить. В метаноле цвет картофеля становится розовым.
Покупать алкоголь только в фирменных, проверенных магазинах.
Каковы основные свойства этилового и метилового спирта?
Слайд 36Домашнее задание
Ответить на следующие вопросы:
Дайте определение предельных одноатомных спиртов и
приведите примеры.
Что такое функциональная группа? Дайте её определение.
Назовите общую формулу
спиртов.Какой суффикс указывает на класс спиртов?
Дайте классификацию спиртов по разным признакам.
Какие виды изомерии возможны для спиртов?
Почему с повышением молекулярной массы предельных одноатомных спиртов растворимость их в воде понижается?